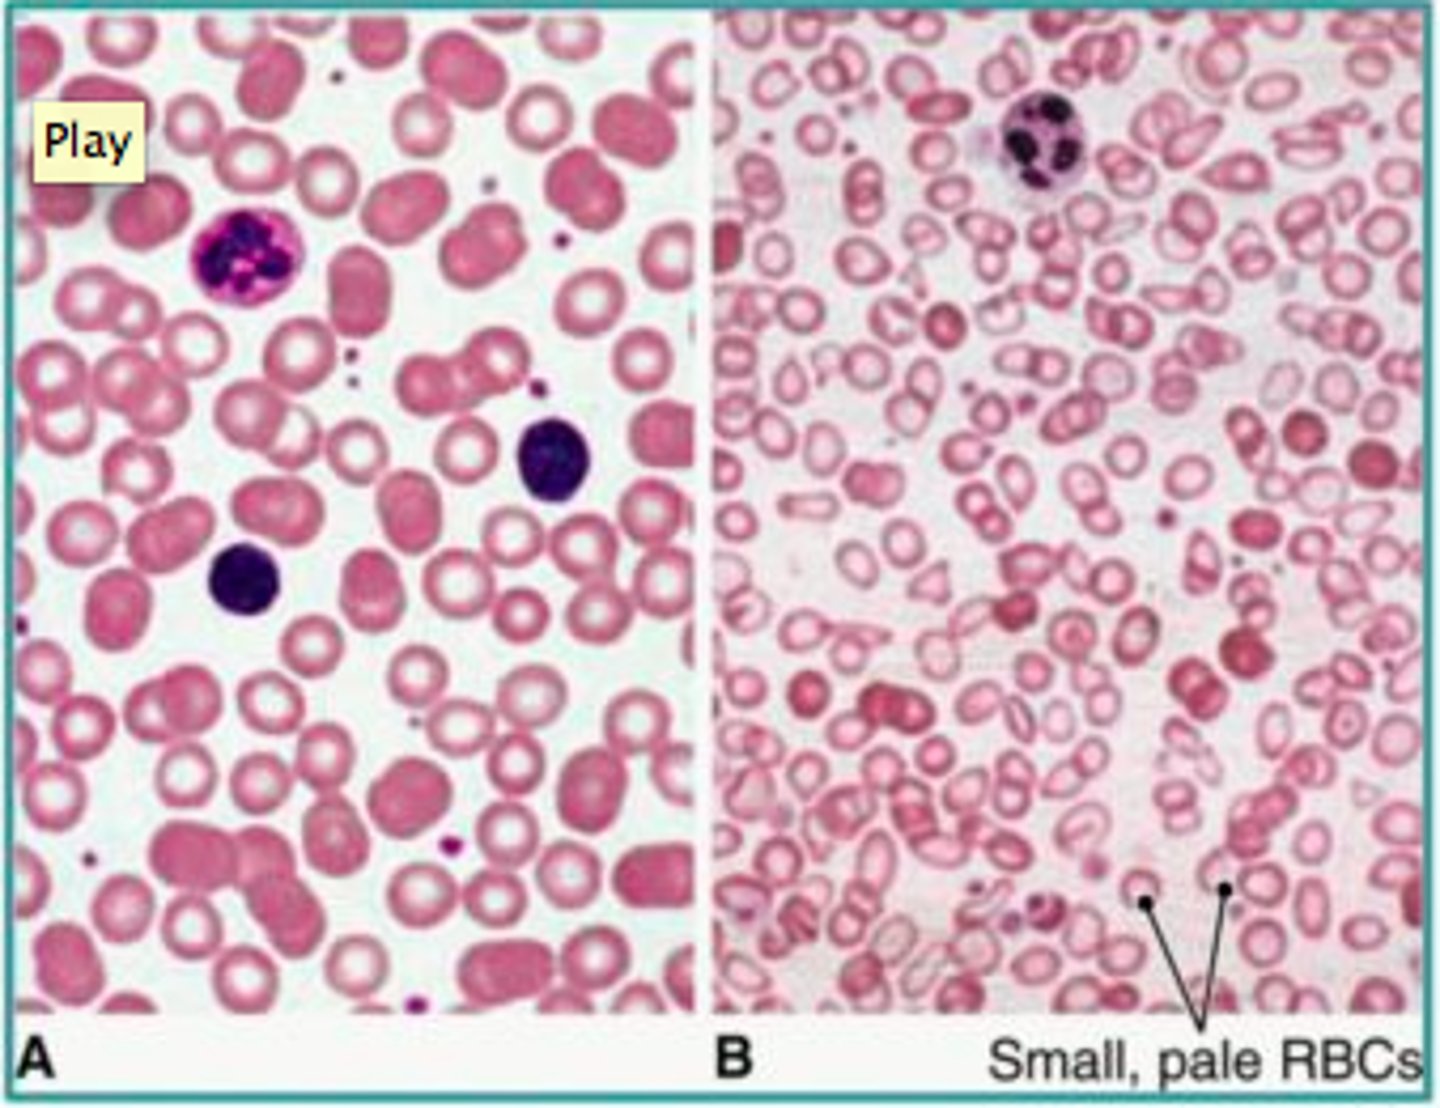
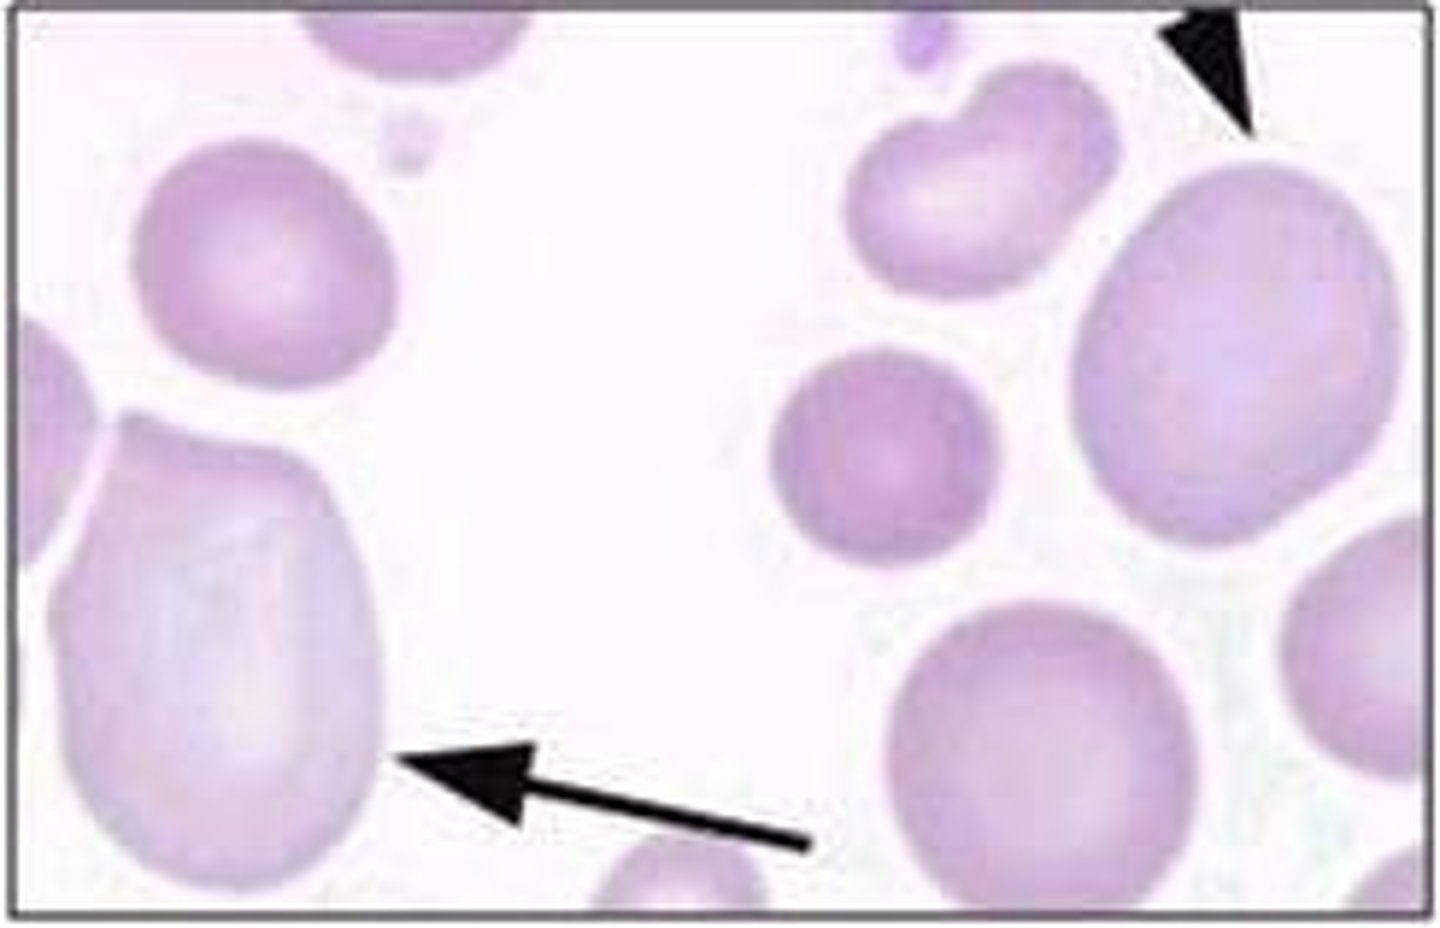

1/126
Looks like no tags are added yet.
Name | Mastery | Learn | Test | Matching | Spaced | Call with Kai |
|---|
No analytics yet
Send a link to your students to track their progress
Hemostasis
To stop or control bleeding; the "halting of blood"

What are the two main steps of hemostasis?
1. Clot formation
2. Clot dissolution
What three components enable hemostasis?
Thrombocytes, the coagulation system, and vascular endothelial cells
Thrombocytes
Non-nucleated fragments of the cytoplasm of megakaryocytes

Where are platelets stored?
1/3 are stored in the spleen

Where do platelets come from?
Megakaryocytes in the bone barrow --> their cytoplasm breaks apart and forms platelets

What triggers the production of platelets?
Thrombopoietin (TPO), which is synthesized in the liver, kidneys and bone marrow

Coagulation system
Clotting cascade --> extrinsic/intrinsic pathways -->
each activated factor catalyzes the next reaction --> fibrin clot

Plasma clotting factors
Substances that promote coagulation; remain inactive in blood until activated --> clotting cascade
Example: Factor X
Natural anticoagulants
Prevent excess coagulation; inactivate clotting factors --> interrupts clotting cascade
Examples: Protein C and S, Plasmin
Intrinsic Pathway
Slow process; activated by an injury inside the blood vessel --> clotting factors are present within the blood and are activated by exposed collagen fibers

Extrinsic pathway
Fast process; activated by injury outside the blood vessel --> clotting factors are located outside the blood and are activated by exposure to tissue factor

Terminal steps of extrinsic pathway
1. Activation of factor X
2. Xa converts prothrombin to thrombin
3. Thrombin converts fibrinogen to fibrin
4. Fibrin strands stabilize the clot
Vascular Endothelial Cells
Squamous cells that line walls of blood vessels

What roles do Vascular Endothelial Cells play in hemostasis?
1. Synthesize and secrete procoagulant factors
2. Prevent the formation of blood clots
Von Willebrand factor (vWf)
A protein synthesized by Vascular Endothelial Cells --> promotes platelet adhesion
Prostacyclin and NO
Proteins released by Vascular Endothelial Cells --> they prevent platelet adhesion
Thrombin inhibitors
Proteins released by Vascular Endothelial Cells, they inhibit thrombin --> interrupts the coagulation pathway --> prevents the formation of a clot
Tissue plasminogen activator (tPA)
Proteins released by Vascular Endothelial Cells, it converts plasminogen to plasmin --> which breaks down the fibrin strands in a blood clot
Stages of hemostasis
1. Vasoconstriction
2. Platelet plug formation
3. Blood coagulation
4. Clot retraction
5. Clot dissolution

Vasoconstriction
What: The narrowing of blood vessels
Why: Neural reflexes, thromboxane A2 (TXA2) released by the platelets

Platelet plug formation
What: Platelets stick together at the injury site
Why: Vascular Endothelial Cells release vWf --> platelets adhere to the exposed collagen --> platelets secrete ADP and TXA2 --> attract more platelets

Blood coagulation
What: The formation of a blood clot
Why: Intrinsic or extrinsic pathway --> factor X --> prothrombin to thrombin --> fibrinogen to fibrin

Step one of coagulation
Factor X is activated by either intrinsic or extrinsic pathway

Step two of coagulation
Prothrombin is converted into the active enzyme thrombin

Step three of coagulation
Thrombin converts fibrinogen to fibrin --> fibrin strands trap RBCs in a jelly substance

Clot retraction
What: The tightening of the fibrin clot
Why: Fibrin strands between the platelets shrink, pulling the two sides of the fissure closer to each other --> clot tightens

Clot dissolution
What: The clot dissolves (fibrinolysis)
Why: Tissue plasminogen activator (tPA) released by the injured tissues --> converts plasminogen to plasmin --> digests the fibrin strands

Hemostatic Disorders
Bleeding and clotting abnormalities
Hypercoagulability states
Conditions that increase clot formation within arteries or veins

Arterial thrombi
Blood clots in the superficial or deep arteries

How does atherosclerosis lead to arterial thrombi?
Deposits of cholesterol and fats in the arteries --> platelets stick to them --> clot forms

How can a splenectomy lead to arterial thrombi?
1/3 of platelets are stored in the spleen --> removal of spleen --> platelets have NO HOME ANYMORE!! --> high platelet count in blood --> thrombocytosis

Venous thrombi
Blood clots in the superficial or deep veins

How can prolonged immobilization lead to venous thrombi?
Long periods of sitting --> blood pools in the veins the legs
This happened to poor Hailey Bieber on the plane and then she had a stroke!
How can pregnancy lead to venous thrombi?
Pregnancy increases the level of plasma clotting factors --> increased risk for thrombi
Superficial thrombophlebitis
Inflammation and clot formation in superficial veins, usually in the leg

Deep vein thrombosis (DVT)
A blood clot in a deep vein, most often in legs

Bleeding disorders
Conditions that result in abnormal bleeding due to the failure of clot formation

Why do bleeding disorders occur?
1. Decrease in thrombocyte count
2. Issues with coagulation system
3. Weakened blood vessels
Thrombocytopenia
Definition: An abnormal decrease in thrombocytes
Causes: Decreases in platelet production, reduced platelet survival, enlarged spleen

Where does spontaneous bleeding occur?
Mucous membranes, under the skin
Purpura
Purple areas of bruising under the skin

Petechiae
Pinpoint hemorrhages under the skin

Von Willebrand Disease
Bleeding disorder caused by a deficiency of von Willebrand factor
NORMALLY, vWf is produced by the blood vessels and reacts with platelets to form a plug --> clot formation
How is Von Willebrand Disease diagnosed?
Usually diagnosed by accident (when surgery or tooth extraction results in prolonged bleeding)
S+S of von Willebrand Disease
Easy bruising, heavy periods, nosebleeds
Type 1 VWD
Person has lower than normal levels of vWf (mildest form)
Type 2 VWD
Person has normal levels of vWf, but it's structure or function is abnormal
Type 3 VWD
Person has very little or no vWf (severest form)
Hemophilia
An X-linked recessive disorder; blood fails to clot properly --> leading to excessive bleeding if injured
Hemophilia A
Factor VIII (8) deficiency --> clotting cascade is interrupted
The letter "A" rhymes with "eight"

Hemophilia B
Factor IX (9) deficiency --> clotting cascade is interrupted
Be mine B9 idk

How is hemophilia diagnosed?
Spontaneous bleeding occurs in the hip, knee, and ankle joints when a child begins to walk

Hemarthrosis
Recurrent bleeding into joint spaces (the classic symptom of hemophilia)

Nonthrombocytopenic Purpura
Bleeding disorder that results from weakened/damaged blood vessels
How can scurvy lead to Nonthrombocytopenic Purpura?
Vitamin C is needed for collagen formation --> lack of collagen leads to weak blood vessels
How can vasculitis lead to Nonthrombocytopenic Purpura?
Inflammation of blood vessels allows pathogens into blood stream --> bacteria/viruses can directly injure blood vessel walls --> causing bleeding
S+S of Nonthrombocytopenic Purpura
Easy bruising, purpura, petechiae, NORMAL platelet count
DIC
Disseminated intravascular coagulation
What is DIC?
Simultaneous, excessive clot formation AND clot dissolution; life-threatening emergency!!

Stage 1 of DIC
Injury/surgery/cancer --> intrinsic/extrinsic pathway activated --> excessive formation of clots

Stage 2 of DIC
Excessive formation of clots --> platelets and clots are used up quickly --> excess bleeding in internal/external organs

Why is the structure of RBCs unique?
The non-nucleated, biconcave disk allows for more room for hemoglobin --> more oxygen
Spectrin and ankyrin
Proteins that help maintain the shape and structure of RBCs
Erythrocytes
Red blood cells

Hemoglobin
The protein that RBCs are composed of

Structure of hemoglobin
2 alpha chains, 2 beta chains, heme groups in the middle of each

Erythropoiesis
The production of red blood cells

What stimulates erythropoiesis?
Erythropoietin (EPO), a colony-stimulating factor synthesized in the kidneys

What stimulates erythropoietin to be released?
Hypoxia (low oxygen in the blood)

Erythroblasts
Immature red blood cells in the bone marrow (nucleated)

Reticulocytes
Immature red blood cells in the blood (non-nucleated)

Life span of a RBC
120 days (4 months)

Bilirubin
A yellow pigment; formed by the breakdown of the heme group of hemoglobin when red blood cells are destroyed --> released by liver in bile

Unconjugated bilirubin (indirect)
Bilirubin circulating in the blood attached to plasma proteins --> insoluble

Conjugated bilirubin (direct)
Unconjugated bilirubin + glucuronic acid --> water soluble --> excreted in urine and bile

Jaundice
A yellowing of the skin and sclera; caused by excess bilirubin in the blood

Icterus
Jaundice

Why does jaundice occur?
Excess destruction of RBC --> causing a buildup of bilirubin
Anemia
A deficiency in the oxygen carrying capacity of RBCs
What are the three main causes of anemia
Low RBCs count, low hemoglobin, or a combination of both
Why does anemia cause fatigue/pallor?
Lack of hemoglobin (red pigment) --> low oxygen and pale skin

Why does anemia cause jaundice?
Excessive destruction of RBCs --> hyperbilirubinemia, jaundice, and pigment gallstones

Why does anemia cause tachycardia?
Low oxygen --> body increases heart rate to compensate

MCV
Mean corpuscular volume

What is MCV?
The average volume and size of individual red blood cells

Microcytic anemia
Anemia characterized by small RBCs (caused by iron deficiency)
Normocytic anemia
Anemia characterized by normal RBCs --> therefore anemia is caused by a low number RBCs

Macrocytic anemia
Anemia characterized by large RBCs (caused by B12 or Folic Acid deficiency)
Iron-deficiency Anemia
Anemia resulting when there is not enough iron to build hemoglobin for RBCs --> small (microcytic) and pale (hypochromic) RBCs
Me af

Causes of Iron-deficiency Anemia
1. Dietary deficiency (ex: veganism)
2. Bleeding (ex: heavy periods)
3. Increased iron demands (ex: adolescence)

Pica
An abnormal craving for nonfood substances (dirt, paint, or clay, ice)
Whenever I'm on my period ALL i want is ice

Koilonychia
Spoon nails, seen in severe iron deficiency

How do you prevent iron-deficiency anemia?
Increase dietary intake, use iron-fortified baby formula

How do you treat iron-deficiency anemia?
Iron supplements, eat vitamin C (helps iron absorption), blood transfusion

Megaloblastic Anemia
Anemia in which the red blood cells are larger than normal
Pathogenesis of Megaloblastic Anemia
Impaired RBC DNA synthesis --> large, immature RBCs are released into the circulation
Causes of Megaloblastic Anemia
B12 or Folic Acid deficiency (both of these vitamins are required for DNA synthesis)

Glossitis
Inflammation of the tongue, seen in severe Megaloblastic Anemia
